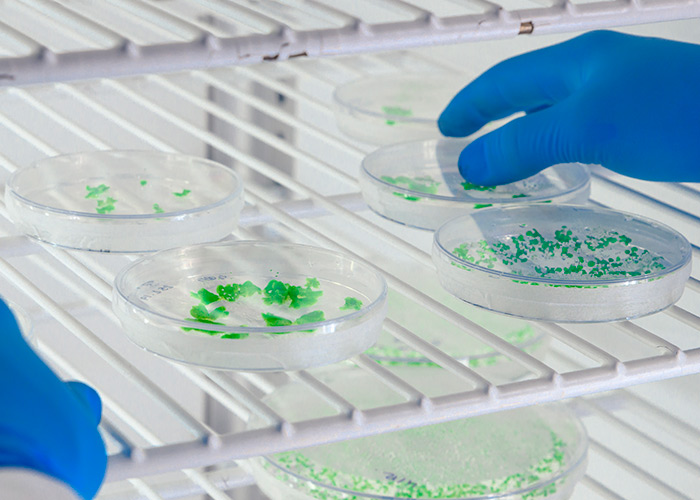
Caracterização de culturas probióticas

De acordo com uma revisão de literatura desenvolvida por pesquisadores chineses, a homeostase da microbiota intestinal pode influenciar a saúde da pele, demonstrando a existência de um eixo intestino-pele. Recentemente, cientistas têm proposto melhorar a saúde da pele por meio de intervenções probióticas. Dessa forma, os cuidados microecológicos com a pele começam a se […]
Mês: janeiro 2025
Distorção da
O transtorno dismórfico corporal, ou dismorfofobia é um distúrbio psiquiátrico que causa sofrimento emocional e preocupação excessiva com um ou mais defeitos corporais hipotéticos. Ao travar uma batalha interna com a própria autoimagem, o indivíduo adota comportamentos extremos, seja para evitar a exposição ou para modificar as áreas corporais desconfortáveis. De acordo com o […]
Caracterização
Quando os pesquisadores fazem a caracterização de culturas probióticas, primeiro é realizado o isolamento e a identificação de gênero, espécie e linhagem. “Temos diferentes cepas da mesma espécie e cada uma delas pode ter um comportamento diferente. Por isso, selecionamos aquela com melhor performance”, acentua. A professora Ana Lúcia Barretto Penna acrescenta que alguns […]
Atividade física intensa
Atletas de alto rendimento são caracterizados por seu metabolismo e fisiologia únicos em comparação a indivíduos sedentários. Ao expor seus corpos a demandas fisiológicas extremas, desencadeiam uma série de processos de adaptação incluindo funções musculares alternadas, reequilíbrio de eletrólitos e síntese de proteínas de fase aguda. Além dos já conhecidos efeitos benéficos no sistema […]
Ação do LcS em indivíduos
A incidência de diabetes mellitus associada à obesidade está aumentando no mundo. A literatura mostra que um estado pré-diabético relacionado à obesidade é caracterizado por anormalidades metabólicas, incluindo hiperglicemia pós-glicose e dislipidemia. Essas condições aumentam o risco de diabetes tipo 2 e de doenças cardiovasculares. Para a prevenção dessas doenças, é necessário o controle […]